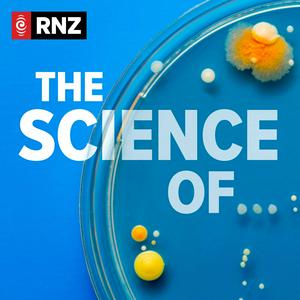

Wastewater
02/9/2024 | 28 mins.
Originally published on Our Changing World, Claire Concannon looks into the science of wastewater.Go to this episode on rnz.co.nz for more details

Vitamin C
24/8/2017 | 37 mins.
What is vitamin C and why do we need it? Which foods have the most vitamin C? Should we pop pills when we think we're getting a cold, or are we just producing expensive urine? And can vit C really cure cancer, or is it all hype?What is vitamin C and why do we need it? Which foods have the most vitamin C? Should we pop pills when we think we're getting a cold, or are we just producing expensive urine? And can vitamin C really cure cancer, or is it all hype? Alison Ballance and Simon Morton are on the case.Experts recommend we consume 200 milligrams (mg) of vitamin C each day.That's easy to do. Two gold kiwifruit (180 mg), three oranges (210 mg) or a cup of frozen blackcurrants (190 mg) are all great sources of vitamin C and will get you to 200 mg in one easy hit.Strawberries (80 mg/cup) and honeydew melon (86 mg/cup) are also high in vitamin C - there's a delicious vit C fruit salad to be made with all these fruits.It'll soon add up on your dinner plate as well. One raw red capsicum contains 240 mg, while kumara (66 mg/cup), cooked broccoli (93 mg/cup) and raw red cabbage (50 mg/cup) are all reliably high.Bananas, apples, carrots and spinach, on the other hand, are all low in vitamin C.Supplement versus food? There is no difference in the quality of vitamin C you get from a pill or food.The scientists we spoke to say there is no need to pop a pill if you eat a healthy diet, including at least 5 servings of fruit and vegetables a day.But they advise taking a supplement if you're getting a cold, as it may shorten the duration of the cold and will stop it developing into pneumonia. Our bodies get rid of vitamin C very quickly, so maybe take small doses of vitamin C often.Vitamin C and scurvyWe've known for hundreds of years that if you don't eat enough fresh fruit and vegetables -especially citrus fruit such as oranges and lemons - you will get scurvy and die.Thousands of sailors died on long ocean voyages until, in the late 1700s, ship captains such as Captain James Cook began taking lemon and lime juice, as well as sauerkraut, on board - and cases of scurvy plummeted.Surprisingly, there are still cases of scurvy reported in New Zealand today - and in a recent study in low income areas of the United States, 12 percent of people were on the verge of scurvy.Ascorbic acid is a vitamin because it's a vital molecule that we don't make ourselves, so we need to get it from food.It wasn't until the early twentieth century that the mysterious molecule that prevents scurvy was identified and named ascorbic acid, which means 'anti scurvy.' Ascorbate is another form of vitamin C.Vitamin C in our body…Go to this episode on rnz.co.nz for more details

Virtual Reality
18/8/2017 | 35 mins.
We go beyond gaming to explore how VR works, what it's being used for (from treating a fear of spiders, to training young doctors) and ask if it's yet making any compelling case to be in every home.From treating a fear of spiders to training young doctors - how real is the promise of Virtual Reality and how is it being used today?Virtual reality, or VR, tricks our brains to immerse us in any reality we can imagine. It was originally developed by the US military in the 1960s, but today it's gamers who are the early adopters driving demand and innovation. Meanwhile, the biggest companies in the world are banking on VR hitting the big time - but no one has yet found that 'killer app' to propel this technology into the mainstream. Will it take another blockbuster game like Pokémon Go, or could VR's uptake be driven by the fact that most of the new smartphones in production today are VR-enabled? What is VR The easiest way to understand VR is to place a finger in front of your eyes, then quickly open and close your right and left eyes; you should see the finger move. Well, it's this movement, or the difference between these images, that provides the 3D quality to images in VR. So a bit like a 3D film, VR shows each eye a different image, and then your brain does all the work to give images depth and create a 3D effect.Dr Wendy Powell is a Reader in Virtual Reality at the University of Portsmouth in the UK. She says that VR revolves around replacing our senses with content that is generated by a computer."Our most dominant senses are our senses of sight and hearing, so in virtual reality, your vision - and usually your hearing - is completely surrounded by computer-generated content, sometimes even your sense of touch as well. Everything you see and hear isn't real, but because it is dominating your vision and your hearing you believe that it is real, and you engage with it is like it is real because you want to believe that it is."Professor Rob Lindeman leads the Human Interface Technology Lab at the University of Canterbury. "Virtual Reality is really this tight coupling between actions by the user and reaction of the system", he says. "So as I turn my head the screens will update what I see ... If the brain receives signals it is expecting, then typically you have an effective virtual experience."Our brains are designed to fill in patterns and missing information, so if you can feed the senses with enough of an experience from a visual and auditory point of view, then our brains will try to complete the picture by filling in what we expect to see…Go to this episode on rnz.co.nz for more details

Sweat
10/8/2017 | 27 mins.
Simon Morton and Alison Ballance present a three-part series exploring the science of sweat, virtual reality and Vitamin C. This week, the function of a much-maligned bodily fluid that plays a vital role in keeping us humans healthy and alive. Human sweat - 99 percent water with a dash of salts and a pH of around 4.5, is a much-maligned bodily fluid that plays a vital role in keeping us humans healthy and alive.The word's become shorthand for hard work and discomfort but without it human life just wouldn't be the same: if our prehistoric ancestors hadn't been able to sweat they could never have stayed cool for long enough to chase down their prey on the ancient Savannah.What happens when we sweat?People sweat for all sorts of reasons; emotional sweating when we're stressed, scared or in pain, or the sweat we get on our forehead when we eat spicy foods. There's the night sweats that people suffer during menopause, and the sweating people experience when they are withdrawing from drugs.But the most common encounter we have with sweat is for thermo-regulation, for cooling us down when we get too hot running for the bus, in humid weather, or when we exercise. When we heat up, the hypothalamus in our brain detects that our body and skin temperature is rising and using a neurotransmitter called acetylcholine it sends a signal to stimulate millions of eccrine sweat glands to release a salty liquid- sweat- via ducts onto our skin to evaporate and cool the body down. These eccrine glands are spread out over most of your body but you have higher concentrations on the palms of your hands, the soles of your feet, your underarms and your forehead. The sweat from these eccrine glands is mostly water and salt and doesn't tend to smell.There's another type of sweat gland called the apocrine gland that can be more problematic. These glands are concentrated in the underarm and groin and from puberty onwards secrete a more oily sweat full of proteins and lipids when you get hot or stressed out and anxious. Although apocrine sweat is sterile when it hits the skin's surface, the bacteria living on you love to eat this gooey goodness, and then excrete the volatile compounds that we sniff as body odour.The role of our microbes in making us smell"Hot and humid, the armpit populated by bacteria cursed with creating a noxious odor. That smell, however, has proved lucrative. Today more than 90 percent of Americans use some sort of armpit cosmetic, creating a worldwide deodorant bonanza worth $18 billion." Terrence McCoy in The Washington Post…Go to this episode on rnz.co.nz for more details

Snow
15/11/2016 | 30 mins.
What is snow? How and where is it made? Why is it white? Alison Ballance and Katy Gosset head to Mt Ruapehu in search of the answers to all your questions about snow.Alison Ballance straps on her skis and her sound recorder, and heads to the slopes of Mount Ruapehu in search of some snowy answers.Along the way, Alison and co-presenter Katy Gosset learn about the snow-making factory high in the sky, about the snap-freezing properties of super-cooled water, how snow flakes are always six-sided and why New Zealand gets wet, heavy snow.Their guide on the ground is snow man Brendon Nesbit, who lives and breathes snow. When he's not forecasting avalanches and heading the ski patrol on New Zealand's Turoa ski field, he is doing the same job at a ski resort in Utah, in the United States.The avalanche forecasting job involves constantly monitoring the weather and the winter snow pack on Mt Ruapehu. Every day, Brendon and his team are digging, poking, prodding, taking the temperature and even tasting the snow on the ground to understand its properties. Their aim is to make the ski field and its users safe from avalanches.Meanwhile, back in Wellington, Metservice extreme weather forecasters Erick Brenstrum and Gerard Barrow have their eyes on the sky. Is there snow forming? Is it cold enough for it to reach the ground or will it melt to rain on the way down?They explain how snow begins life as a tiny ice crystal, created when water gas freezes around a tiny bit of dust or even bacteria. And they explore the differences in snow weather, between a southerly outbreak and a northerly over-running situation, and what effect that has on the ground.And NIWA's Christian Zammit points out that snow isn't just of interest to skiers - melting snow supplies water to farms and towns, and also produces most of New Zealand's hydro-electricity.Check out the Eyewitness podcast on the Everest avalanche, to find out what it's like to witness a large avalanche with many fatalities and injuries.Go to this episode on rnz.co.nz for more details

The Science Of…